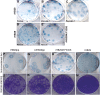

Reverse genetics system for severe fever with thrombocytopenia syndrome virus
- PMID: 25552716
- PMCID: PMC4337530
- DOI: 10.1128/JVI.03432-14
Reverse genetics system for severe fever with thrombocytopenia syndrome virus
Abstract
Severe fever with thrombocytopenia syndrome virus (SFTSV) is an emerging tick-borne pathogen that was first reported in China in 2009. Phylogenetic analysis of the viral genome showed that SFTS virus represents a new lineage within the Phlebovirus genus, distinct from the existing sandfly fever and Uukuniemi virus groups, in the family Bunyaviridae. SFTS disease is characterized by gastrointestinal symptoms, chills, joint pain, myalgia, thrombocytopenia, leukocytopenia, and some hemorrhagic manifestations with a case fatality rate of about 2 to 15%. Here we report the development of reverse genetics systems to study STFSV replication and pathogenesis. We developed and optimized functional T7 polymerase-based M- and S-segment minigenome assays, which revealed errors in the published terminal sequences of the S segment of the Hubei 29 strain of SFTSV. We then generated recombinant viruses from cloned cDNAs prepared to the antigenomic RNAs both of the minimally passaged virus (HB29) and of a cell culture-adapted strain designated HB29pp. The growth properties, pattern of viral protein synthesis, and subcellular localization of viral N and NSs proteins of wild-type HB29pp (wtHB29pp) and recombinant HB29pp viruses were indistinguishable. We also show that the viruses fail to shut off host cell polypeptide production. The robust reverse genetics system described will be a valuable tool for the design of therapeutics and the development of killed and attenuated vaccines against this important emerging pathogen.
Importance: SFTSV and related tick-borne phleboviruses such as Heartland virus are emerging viruses shown to cause severe disease in humans in the Far East and the United States, respectively. Study of these novel pathogens would be facilitated by technology to manipulate these viruses in a laboratory setting using reverse genetics. Here, we report the generation of infectious SFTSV from cDNA clones and demonstrate that the behavior of recombinant viruses is similar to that of the wild type. This advance will allow for further dissection of the roles of each of the viral proteins in the context of virus infection, as well as help in the development of antiviral drugs and protective vaccines.
Copyright © 2015, American Society for Microbiology. All Rights Reserved.
Figures

References
-
- Plyusnin A, Beaty BJ, Elliott RM, Goldbach R, Kormelink R, Lundkvist Å, Schmaljohn CS, Tesh RB. 2012. Bunyaviridae, p 725–741 InKing AMQ, Adams MJ, Carstens EB, Lefkowits EJ (ed), Virus taxonomy: ninth report of the International Committee on Taxonomy of Viruses. Elsevier Academic Press, London, United Kingdom.
-
- Plyusnin A, Elliott RM (ed). 2011. Bunyaviridae: molecular and cellular biology. Caister Academic Press, Norfolk, United Kingdom.
-
- Elliott RM, Schmaljohn CS. 2013. Bunyaviridae, p 1244–1282 InKnipe DM, Howley PM (ed), Fields virology, 6th ed Wolters Kluwer, Philadelphia, PA.
-
- Bouloy M. 2011. Molecular biology of phleboviruses, p 95–128 InPlyusnin A, Elliott RM (ed), Bunyaviridae: molecular and cellular biology. Caister Academic Press, Norfolk, United Kingdom.
Publication types
MeSH terms
Substances
Associated data
- Actions
- Actions
- Actions
Grants and funding
LinkOut - more resources
Full Text Sources
Other Literature Sources
Molecular Biology Databases